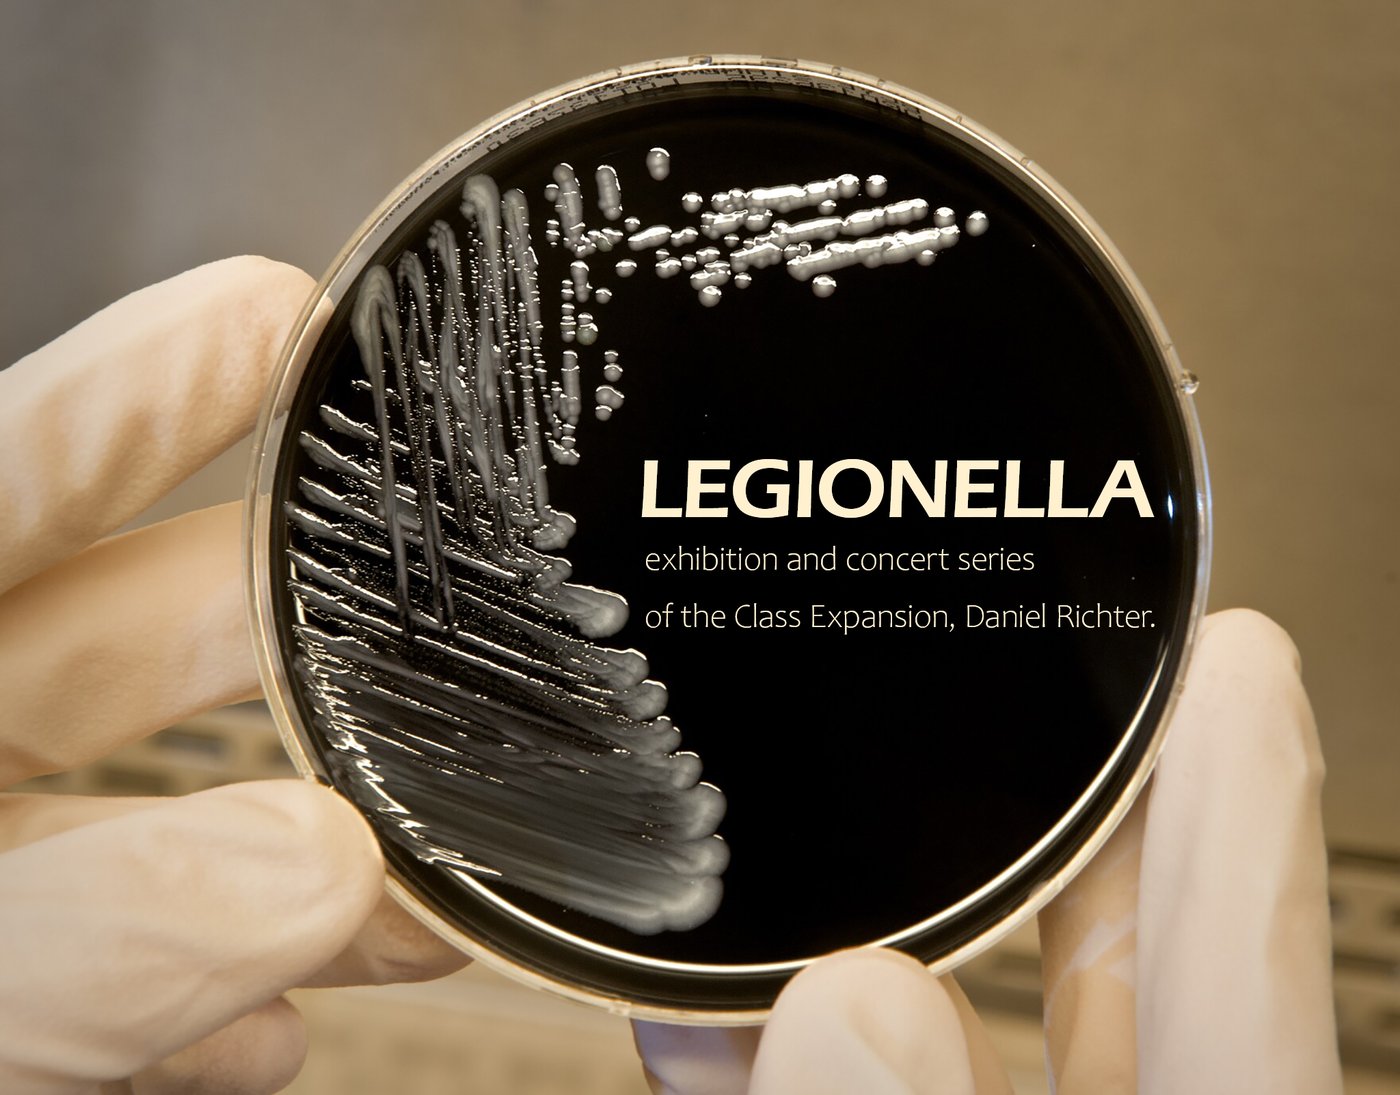

LEGIONELLA
Die Veranstaltung Legionella lädt zu einer Konzertreihe und Ausstellung ein, in der alle Atelierteilnehmer_innen der Expansion-Klasse unter der Professur von Daniel Richter vertreten sind.
Die Ausstellung findet im Rahmen des Rundgangs vom 22.–25. Januar 2026 statt.
Konzert:
22. Januar 2026, ab 19 h
Music by Rottweil Band, Alexander Zaloopin, Ingwa, Gudyear